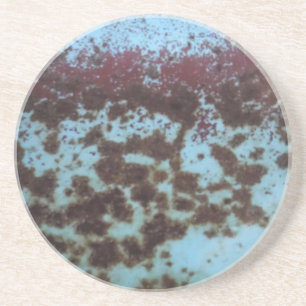
Teal Blue & Purple Rusted background Coaster

Popular Truck Coasters
1977 TRANS AM STONE COASTER
Price£12.05
custom deluxe pink and white coaster
Price£12.50
Asphalt Street Coaster
Price£11.80
Fire Chief Flames Stone Coaster
Price£12.50
Fire Chief Maltese Cross Stone Coaster
Price£12.50
St. LOUIS FIRE DEPARTMENT. Coaster
Price£33.75
Vintage soft blue rusted coaster
Price£12.50
1937 PACKARD STONE COASTER
Price£12.40
SERIES STONE COASTER
Price£12.05
Firefighter Logo Coaster
Price£33.80
Teal Blue & Purple Rusted background Coaster
Price£33.80
Rusty Blue background Coaster
Price£33.80
Neon Tacos Symbol Coaster
Price£11.80
Junk Yard vintage car 50's teal aqua Coaster
Price£33.80
Artful Fire Truck on Round Paper Coaster
Price£1.85
Big Yellow Excavator Coaster
Price£12.05
TIMELESS STONE COASTER
Price£12.05
Star Tag Decal Navy Blue Camo Coaster
Price£12.30
Teal Blue Pink Green rusted Coaster
Price£12.50
Teal Blue & Purple Rusted background Coaster
Price£12.50
Poodle Christmas Stone Coaster
Price£15.15
Rusty Blue background Coaster
Price£12.50
Bright blue vintage coaster
Price£33.80
Kids Construction Dumptruck Coaster
Price£33.80
Fun Design for the Kid in All of Us! Coaster
Price£13.60
Happy Birthday Fire Truck Coasters
Price£1.55
Junk Yard vintage car 50's teal aqua Coaster
Price£12.50
Vintage Blue Door, Silver Handle Coaster
Price£33.80
Turquoise Blue Rusted Coaster
Price£12.50
The Zazzle Promise
Love It Guarantee
Don't love it? We'll take it back! 30-day returns “100% Love It Guarantee.”
Easy International Delivery
Hassle-free shipping with no surprise fees. We cover any customs & duties.
Secure Shopping Guaranteed
100% Secure payment with SSL Encryption.
Search Feedback
If you need help or have a question for Customer Service, please visit our Help Centre
Recently Viewed Items